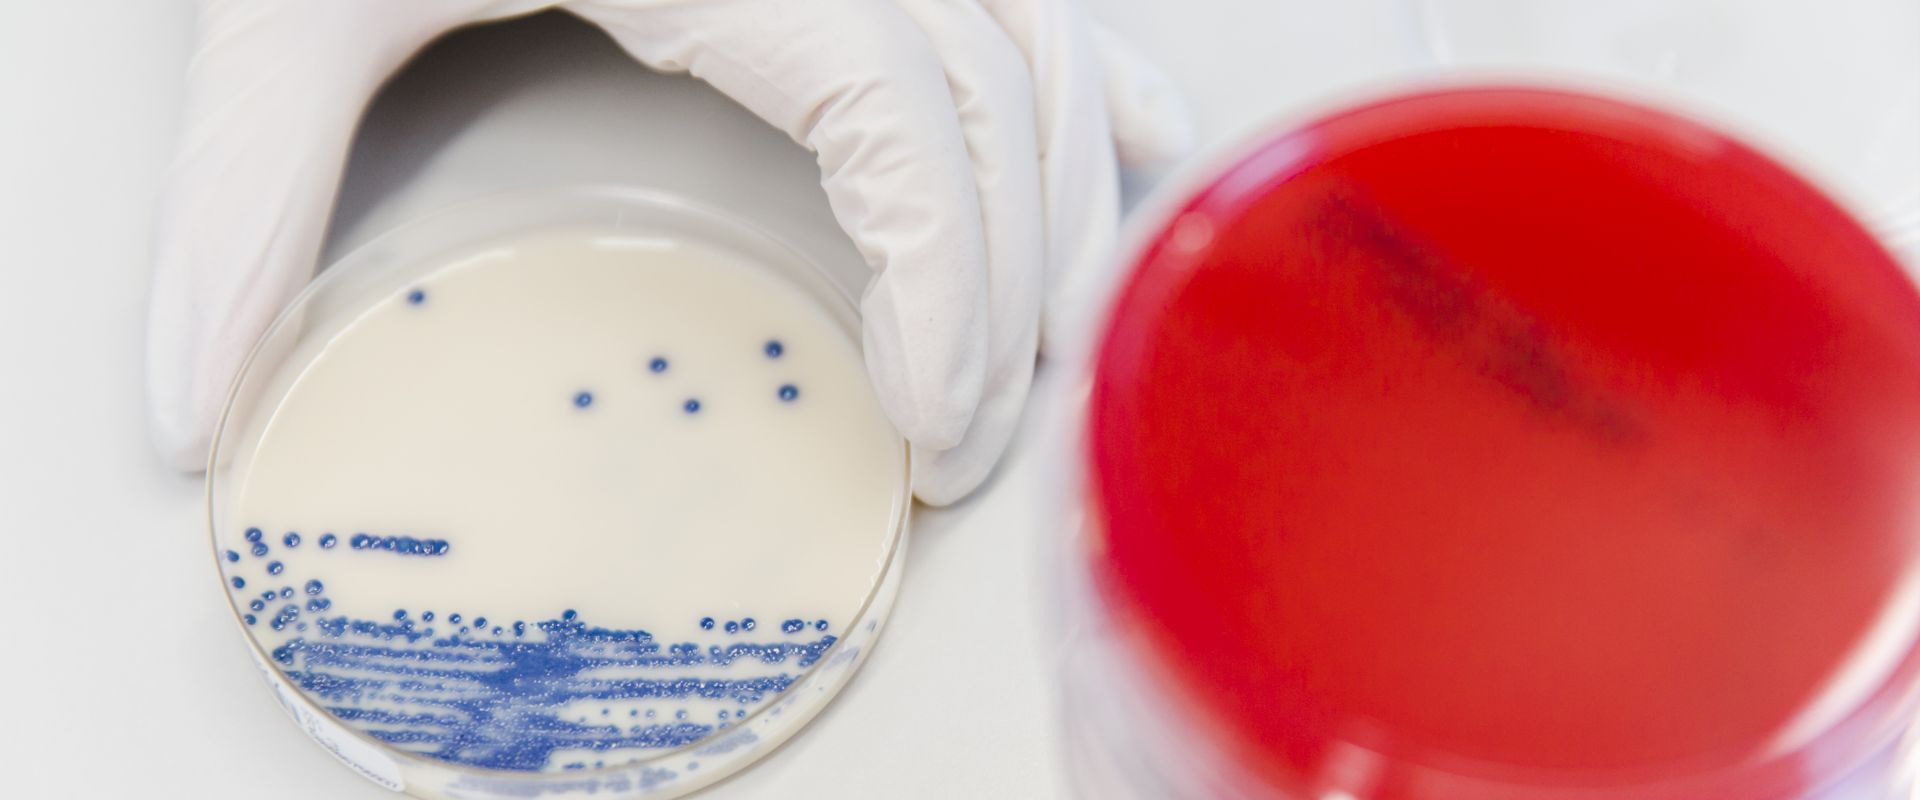
Keyvisual Firmenprofil 4 Keyvisual Firmenprofil 4

Wir als Arbeitgeber
Fakten deutschlandweit
> 380
Mitarbeiter
4
Standorte
> 10.000
Aufträge pro Arbeitstag
Benefits & Work-Life-Balance
Benefits

Jobs
Wir suchen in den folgenden Berufsgruppen
Kontakt
Eurofins Laborbetriebsgesellschaft Gelsenkirchen GmbH
Rotthauser Straße 19, 45879 Gelsenkirchen, Deutschland
Email: info@gelamed.de
Kontakt aufnehmen